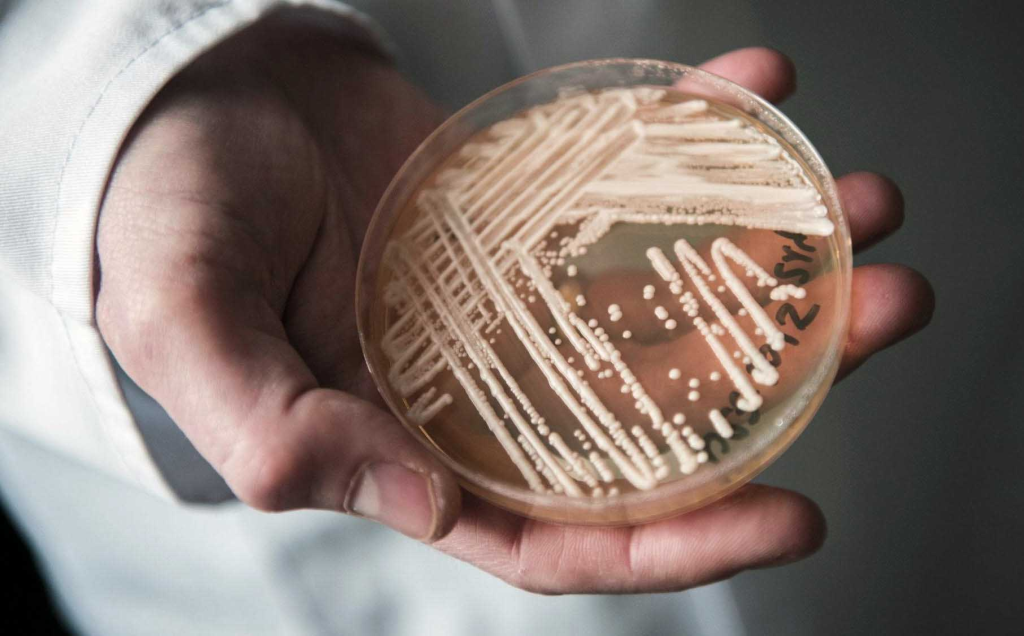
image 2

美国公共卫生系统正在应对一场“看不见、却越来越近”的感染挑战:一种耐药性极强、在医疗机构内特别容易传播的真菌——Candida auris(C. auris,常译“耳念珠菌”)——正持续在美国多地出现病例并引发院内暴发风险。美国疾病控制与预防中心(CDC)长期把它列为重点监测对象,并在其官方专题页面中明确指出:自2016年美国首次报告以来,C. auris 的临床病例一直呈上升趋势,且对医疗系统的感染控制提出更高要求。
你可能会问:真菌感染不是“脚气、灰指甲”那种吗?为什么这次会让CDC持续发声、医院如临大敌?
答案在于:C. auris 不是普通表浅真菌,它更像“真菌界的超级耐药病原体”,常在重症病房、养老院、长期护理机构等场景中造成难控传播,并可导致血流感染等严重后果。

这是一种怎样的真菌?它从哪里来、为什么突然“全球冒头”?
Candida auris 最早在2009年于日本被报告分离(最初与耳部感染相关,因此中文常见“耳念珠菌”的叫法)。此后,它在多个国家和地区被陆续发现,并在一些地方出现“医院内聚集性传播”。一些学术综述强调,C. auris 的“诡异之处”在于:它并非像很多病原体那样从单一地区逐步扩散,而是呈现出多地几乎同期出现、遗传谱系不同的特点,这也让其起源与驱动因素成为研究热点。
在美国,CDC明确记录:美国首例报告在2016年之后被纳入持续监测,并逐年公布病例趋势。CDC在“Tracking C. auris(追踪)”页面中解释了数据口径:病例由州与地方卫生部门上报,并依据既定病例定义(case definition)区分不同类型的“病例”。
为什么它这么危险?——“超级真菌”的危险点,不止是致死率
你原文里说它“顽固”“像超级细菌级别”,这个判断方向是对的,但为了更专业、更易懂,我们把危险点拆成四个层面讲清楚:
危险点1:它能造成“侵袭性感染”,不是皮肤表面问题
很多人对真菌的印象停留在皮肤、指甲,但 C. auris 在医疗场景中更令人担心的是:它可以引发侵袭性/深部感染(例如血流感染),而这类感染往往发生在本来就很脆弱的人群身上:重症患者、免疫功能受损者、术后患者、长期卧床者等。CDC也强调它常与住院环境相关,并可在住院患者中导致严重多重耐药疾病。
危险点2:耐药性强,治疗选择被“压缩”
C. auris 最被称为“超级真菌”的核心原因之一,是它对多种抗真菌药物可能不敏感。临床上,棘白菌素类(echinocandins)通常是成人及较大儿童首选方案;但CDC也提醒:耐棘白菌素以及“泛耐药(pan-resistant)”病例报告在增加,必要时甚至需要考虑研究性/试验性用药。
此外,学术研究也在持续解析“泛耐药”菌株为什么会同时对多类抗真菌药物产生抵抗,这进一步说明:耐药不是单点问题,而是可能涉及多基因、多机制的复杂演化。
危险点3:它特别擅长在医疗环境“赖着不走”,消毒不当就反复出现
你原文提到它能在设备、床架、地板等表面存活,这非常关键。CDC的感染控制指南明确提醒:仅依赖季铵盐类(QACs)的消毒产品对C. auris无效,医院环境消毒必须使用对C. auris有效、且经过EPA注册的医院级消毒剂。
更现实的一点是:很多日常清洁产品的有效谱并不包含 C. auris,而医院消毒也需要“对症下药”。一项针对多种常用液体消毒剂的研究就指出:具备杀孢子能力(sporicidal)的消毒剂更稳定有效,而季铵盐类活性有限。
危险点4:它可“定植”在人身上很久——没症状也可能带菌
这是很多大众科普容易漏掉、但对理解传播至关重要的点。CDC在病例定义与操作指南中提到:一个人如果被定植或感染 C. auris,通常会被认为可能长期/持续定植;因此公共卫生部门会区分:
- 筛查阳性(screening case):为了“找带菌者”而做的定植筛查拭子(不一定有症状)
- 临床病例(clinical case):因诊疗需要,从临床标本中检出(通常意味着与疾病相关、需要治疗评估)
这也解释了为什么同一家机构里,即使“治疗了一个病人”,仍可能因为其他带菌者存在而继续出现传播链。

“健康人可能能自愈”?这里需要更严谨地说清楚
你原文写“健康人可能能自愈”,为了更专业、避免医学表述风险,建议改成更准确的说法:
- CDC总体判断是:C. auris 主要威胁住院或医疗照护环境中的高风险人群,对一般健康人群不构成同等层级的威胁;
- 但在家庭层面,如果家里有人处于高风险状态(长期护理、带导管、近期大手术、免疫抑制治疗等),就不能简单按“健康人不怕”来理解,而要按医疗机构的感染控制逻辑来提高警惕。

🧬 科学家:气候变暖可能是“帮凶”——但这仍是“假说+证据积累中”的科学讨论
你引用了“体温是天然防线、全球变暖让真菌更耐热”的观点,这确实来自学界提出的一个重要解释框架:“全球变暖驱动真菌热适应,从而更可能跨越人体温度屏障”。相关论文把它称为“全球变暖出现假说(global warming emergence hypothesis)”,核心逻辑是:如果环境温度整体升高,部分环境真菌会逐步获得耐热性,进而更可能在人体温度下生存与传播。
不过网页发布时建议你加一句“科学严谨的限定语”:
- 目前主流观点是:气候变暖可能是推动因素之一,但 C. auris 的出现与传播也可能与医院感染控制压力、抗真菌药物使用、全球人口流动、检测能力提升等多因素共同作用有关。学界对“多因素叠加”的框架讨论也非常多。
这样写既保留了亮点,也避免“单因果解释”被专业读者质疑。

感染数据触目惊心:到底该看哪些数字?——教你读懂“临床病例 vs 筛查病例”
很多社交媒体会直接报“今年感染7000”“多少州告急”,但做网页内容更建议你把官方可核对的数据放在主表述,把“媒体口径”放在补充说明里。
1)CDC官方可核对的趋势数据
CDC追踪页面明确写到:2023年美国新增 4,514 例 C. auris 临床病例(clinical cases),并说明自2016年首次报告以来一直在上升;同时CDC也指出:与早些年相比,自2022年以来同比增幅有所放缓,但总体仍处高位。
此外,CDC的 NNDSS(国家法定传染病监测系统)也提供了“Candida auris, clinical”按周的 provisional(暂定)统计表,提示这些周报数据会随着各地上报更新而调整。
2)为什么你会看到“州数不一致”?
你原文写“27州报告”,但CDC在2023年的统计口径里曾出现“覆盖到36州+华盛顿特区”的汇总说法(基于州上报数据的整理报道也提到这一点)。这类差异通常来自:
- 统计年份不同(你看到的是2025媒体口径,而CDC公开汇总可能截至2023/2024更新);
- 口径不同(临床病例 vs 筛查定植 vs 历史累计 vs 年新增);
- 某些州数据更新滞后或上报方式不同。
3)关于“2025年7000例”的说法,建议这样处理更稳妥
我检索到的“2025年感染至少7000人”的表述主要来自个别媒体/资讯站的转述,并非CDC在其追踪页面上直接给出的年度官方汇总数字(CDC公开页面目前清楚列出的最新年度数字是2023年的新增临床病例4,514)。
因此,为了既“信息丰富”又“可守住事实边界”,建议你在文章里这样写:
- 主文:以CDC已公开的年度数据与趋势为准;
- 补充框:说明“有媒体援引联邦卫生官员/数据称2025年病例更高”,但提醒读者“需以CDC后续官方年度汇总为准”。
这种写法最适合媒体机构网页发布:既不落后,也不冒进。

高风险场所包括:医院、养老院、长期护理机构——为什么这些地方最容易“中招”?
你原文的“高风险场所”判断非常准确,建议扩写为更具体的“传播链条解释”:
- 人群高度脆弱:住院患者、长期护理人群基础病多、免疫力低、皮肤屏障差;
- 侵入性操作频繁:导尿管、中心静脉导管、呼吸机、透析等,为病原体进入体内提供通道;
- 环境接触密集:同一台设备、同一护理团队、同一病区反复接触,若感染控制不到位就容易交叉传播;
- 带菌者未必有症状:定植者不“发病”,却可能让病原体在机构内持续存在。
医疗系统怎么防?CDC给医院的“硬核清单”其实与我们每个人有关
为了让文章更“可操作”,建议你把CDC要点翻译成大众能执行的语言:
医院层面(专业感染控制核心)
- 接触隔离(Contact Precautions):对确诊或疑似患者采取隔离措施;
- 环境消毒要用“对C. auris有效”的产品:CDC强调仅用QAC类不够,推荐用EPA登记且对 C. auris 有效的医院级消毒剂;EPA也专门维护了“对Candida auris有效产品清单”。
- 筛查与溯源:在暴发风险机构,对高风险患者做定植筛查,尽早找出“沉默带菌者”;
- 实验室鉴定能力:避免误判为其他念珠菌,缩短确诊时间、尽快启动隔离与治疗路径。
家庭层面(普通人真正用得上的部分)
如果你家人正在住院或住在护理机构,以下做法很关键:
- 探视时配合洗手与防护要求:进出病房都洗手,必要时按医院要求穿戴防护;
- 不要自行带“家用湿巾”替代医院消毒流程:院内消毒需要专业产品与流程;
- 关注“导管/管路护理”是否规范:很多严重感染与管路相关;
- 不要自行要求或滥用抗生素/抗真菌药:不当使用会加速耐药问题。

放到“教育人群”语境:留学生、寄宿家庭、校园健康需要知道什么?
北美教育快报的读者里有很多留学生家庭、寄宿家庭、以及在医疗系统/护理系统学习或实习的人群(护理、公共卫生、生物医学)。你可以加一个“教育快报专栏角度”的扩写段落,让文章更贴合受众:
- 对大多数在校学生:C. auris 的主要风险不在校园日常社交,而在医疗照护环境;不需要恐慌式囤药或过度消毒。
- 对护理实习/医院志愿者:要把它当成“必须严守手卫生与接触隔离”的重点病原体;尤其在ICU、长期护理机构轮转时,更要严格按流程做手套/隔离衣使用与环境清洁。
- 对有基础病或免疫抑制的学生/家属:一旦近期频繁就医、留置管路、或长期住院护理,建议主动向医疗团队询问机构感染控制措施与筛查策略(这在美国是很常见也被鼓励的沟通)。

你知道你所在州有没有相关病例吗?——建议读者这样“靠谱对照”
你原文结尾的互动很适合网页传播,但建议把“对照方式”也写得更权威:
- 优先看 CDC 的追踪页面(按州/按年数据);
- 若想更快看到变化,可参考 NNDSS 周报数据(但要提示“周报是暂定数据,会回填修订”);
- 如果读者在欧洲,也可参考 ECDC 关于 C. auris 在欧洲医疗系统扩散的调查与通报(用于对照全球趋势)。
结语:它不是“下一次社区大流行”的典型模式,但它是医疗系统必须硬扛的长期战
把这篇文章写得更“专业可信”的关键,是你要明确一个主线结论:
- C. auris 更像“医疗体系内的耐药慢性威胁”:它考验的是医院、养老院、长期护理机构的感染控制能力、检测能力与跨机构协作,而不是普通人日常出门戴口罩就能解决的问题。
- 同时,WHO也已将包括 Candida auris 在内的多种真菌列为“优先关注的真菌病原体”,强调全球在诊断、药物研发和监测方面存在缺口。






